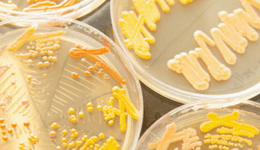
width=

Food Agriculture
News Digest #205 – Hexafly Raises $1.3M to Farm Insects, Biotech Needs Better Stories, and More
Hi all,How can we make the world aware of the existence of a potentially world-changing scientific advancement? This week, Yan Liu discusses why biotech needs better external innovation networks and think tanks.In other news, Hexafly raised $1.3 million to farm insects to develop materials for the aquaculture, chitin and plant nutrition industries, and Twist Bioscience is bringing the power of DNA writing to amplify and enrich the process of DNA reading with the launch of new products. Don't miss Emily Leproust speaking at SynBioBeta 2018.

CTO John Lynam, CSO Laura Healy, CEO Alvan Hunt & Marketing Lead Darren Brennan ©HexaflyLGC announced that it has acquired Lucigen Corporation, a leading supplier of life science products targeting applications in clinical diagnostics, drug discovery, synthetic biology and gene editing. Finally, check out Fatma Kaplan's article on composite biopesticides, an ecologically friendly option for controlling pests. She will be speaking at SynBioBeta 2018.Enjoy the rest of your week.Regards,John

KnipBio Announces Aquafeed Ingredient
KnipBio developed a line of fish meal that contains bio-astaxanthin, a carotenoid that gives fish health benefits.
In the future we won’t edit genomes—we’ll just print out new ones
Why redesigning the humble yeast could kick off the next industrial revolution.

Hacking the immune system
Synthetic biologist Wendell Lim of the University of California, San Francisco, studies how immune cells process information and make decisions, and how to harness those abilities for medicine.

UCLA scientists develop low-cost way to build gene sequences
The approach, DropSynth, makes it possible to produce thousands of genes at once for just a few dollars apiece.

RebelBio Partners With Clustermarket
The partnership will support RebelBio’s startups and will provide them streamlined access to state of the art instruments and services.

Data support advancement of Synthetic Biotic medicines as immuno-therapies
Synlogic presents data that demonstrate the antitumor effects of treatment with a probiotic strain of engineered E.coli.
Who's Hiring?
Scientist – Synthetic Biology at DeepBiome Therapeutics, Allston, MAHead of Metabolic Engineering: Bayer and Ginkgo Joint Venture, Boston, MAJunior Molecular Biologist: Ginkgo Bioworks, Boston, MATo feature your job here, please get in touch
All the News
Pausing evolution makes bioproduction of chemicals affordable and efficientLab grown fabrics may be the future of eco-friendly clothing (CNN Tech)Tweaking Life’s Information-Processing Platform Could Simplify the Development of Biotech and Healthcare Apps (GEN)CRISPR Race 2.0: Doudna and Zhang Compete on a CRISPR Diagnostic (Xconomy)After more than 30 years, genetically engineered salmon may be coming to a store near you (bioGraphic)As Mass Extinction Looms, Conservation Genomics Fights Back (Techonomy)Did Pox Virus Research Put Potential Profits Ahead of Public Safety? (NPR)Genetic engineering promises cornucopia of future products—but biotechnology critics take lethal aim (Genetic Literacy Project)The crop microbiome holds the future of fertilizerSynthetic ‘nanofactory’ cell produces anti-cancer drugs within tumour (Silicon Republic)PLOS iGEM Realtime Peer Review Jamboree – February 23rdNew Sustainable Production Method Could Advance Plastics and Pharmaceuticals
Copyright © %%current_year_YYYY%%, All rights reserved.SynBioBeta1547 Palos Verdes Mall, #411Walnut Creek, CA 94597About Us

















